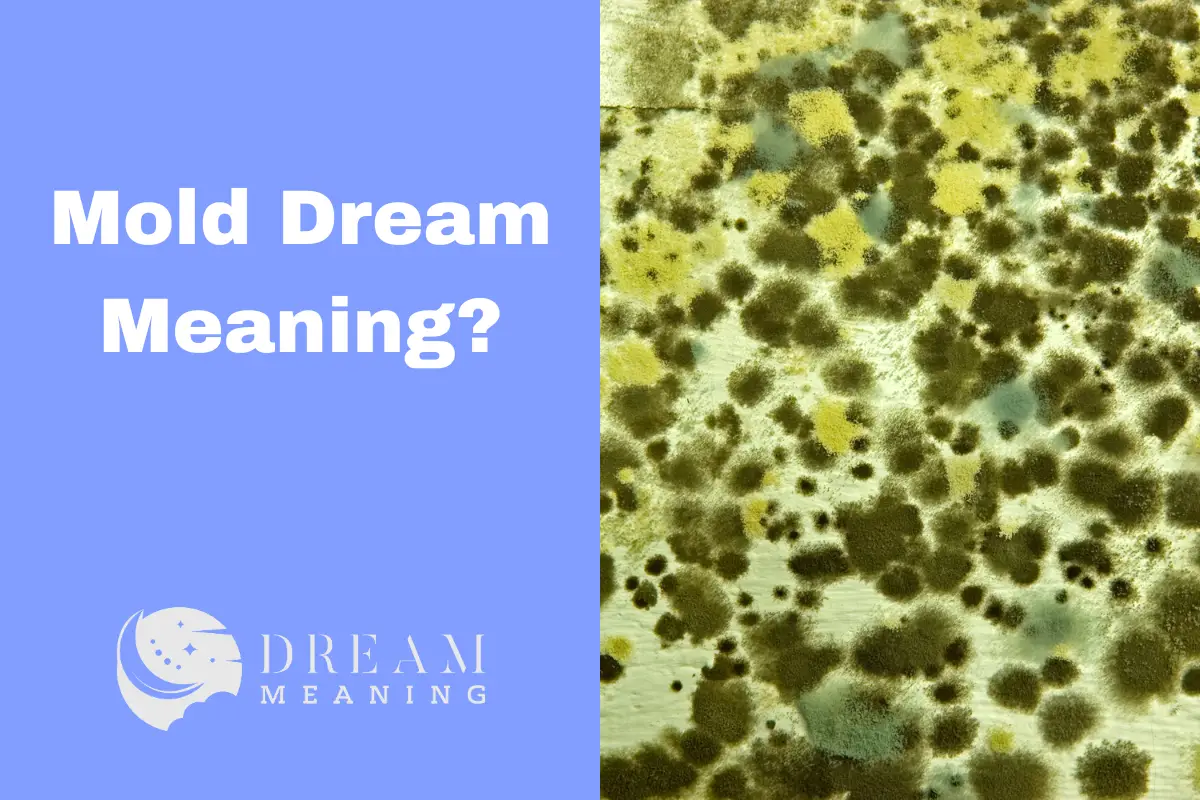
Mold Dream Meaning: Uncover the Hidden Messages in Your Dreams - The

← mole meaning in english Mole meanings moles meaning what is spanish mole Mole mexican poblano →
If you are searching about What is Mold? - MoldInspection.ca you've came to the right web. We have 35 Pics about What is Mold? - MoldInspection.ca like Mold - Day of the Word, Mold Dream Meaning: Uncover the Hidden Messages in Your Dreams - The and also What Is Mold: Mold Definition, Signs, What To Do If You Spot It. Here it is:
What Is Mold? - MoldInspection.ca
 www.moldinspection.ca
www.moldinspection.ca
Hold The Mold - RHI
 yourrhi.com
yourrhi.com
Mold Definition: Understanding Types, Dangers, And Removal
 oasismedicalinstitute.com
oasismedicalinstitute.com
Mold And Mildew - Do You Know The Difference Between The Two? | A&J
 ajrestores.com
ajrestores.com
mold mildew difference between covid reopen reoccupation ready plan information surfaces drywall
What Is Mold? - MoldInspection.ca
 www.moldinspection.ca
www.moldinspection.ca
Mold - Day Of The Word
 dayoftheword.com
dayoftheword.com
About Mold
 envab.com
envab.com
mold toxic
The Key To Mold Control Is Moisture Control - Infographic | US EPA
 www.epa.gov
www.epa.gov
Definition & Meaning Of "Mold" | Picture Dictionary
 dictionary.langeek.co
dictionary.langeek.co
What Is The Meaning Of Mould And Mold? | PDF
 www.slideshare.net
www.slideshare.net
What Is The Meaning Of Mould And Mold? | PDF
 www.slideshare.net
www.slideshare.net
What Is Mold: Mold Definition, Signs, What To Do If You Spot It
 www.moldact.com
www.moldact.com
Unveiling The Spiritual Meaning Of Mold: A Deep Dive
 mindfulspirituallife.com
mindfulspirituallife.com
Mold Dream Meaning: Uncover The Hidden Messages In Your Dreams - The
thedreammeaning.com
thedreammeaning.com
Mold Vs. Mould—Which Is Correct? (Grammar + Examples) | GrammarBrain
 grammarbrain.com
grammarbrain.com
What Is Mold And What Does Mold Look Like? | Mold Busters
 www.bustmold.com
www.bustmold.com
mold what does look like
Spanish - Intro To Mold And Mildew Hazards
 www.oshaonlinecenter.com
www.oshaonlinecenter.com
Mold Past Tense: Verb Forms, Conjugate MOLD - GrammarTOP.com
 grammartop.com
grammartop.com
mold tense forms
Mold Certification Training (Spanish) Get Safety Cert Today
 hardhattraining.com
hardhattraining.com
Mold And Mould | Meaning, Examples & Difference | Promova
 promova.com
promova.com
Is This Mold In My Spanish Roll????? : R/foodsafety
 www.reddit.com
www.reddit.com
Interesting Mold Facts | Certified Mold Inspections
 findingthemold.com
findingthemold.com
mold
How Do You Say Mold In Spanish - Find Property To Rent
 filmsnfbfyoq.blogspot.com
filmsnfbfyoq.blogspot.com
What Is Mold And How To Treat It | Mold Removal
 real-101.com
real-101.com
MOLD Definition And Meaning | Collins English Dictionary
 www.collinsdictionary.com
www.collinsdictionary.com
What Is Mold?
 www.themoldpros.com
www.themoldpros.com
mold
Mold Past Tense: Verb Forms, Conjugate MOLD - GrammarTOP.com
 grammartop.com
grammartop.com
mold tense past grammartop
What Is The Meaning Of Mould And Mold? | PDF
 www.slideshare.net
www.slideshare.net
Mold Health Issues: Ideas For Parents To Keep Their Kids Safe
 theparentsmagazine.com
theparentsmagazine.com
Mold Definition: What Is Mold? (2024) & Wyndly
 www.wyndly.com
www.wyndly.com
What Is Mold
 www.properties.rent
www.properties.rent
Why Understanding Mold Is Crucial: Examining The Risks And Impact On
 mold-heal.com
mold-heal.com
What Is Mold? – Health.Gov.Capital
 health.gov.capital
health.gov.capital
Mold Or Mould: What's The Correct Spelling? | Mold Busters
 www.bustmold.com
www.bustmold.com
mold mould comments
Unpacking The Meaning Behind Dreaming Of Mold
 symbolwave.com
symbolwave.com
What is the meaning of mould and mold?. Mold definition and meaning. Interesting mold facts